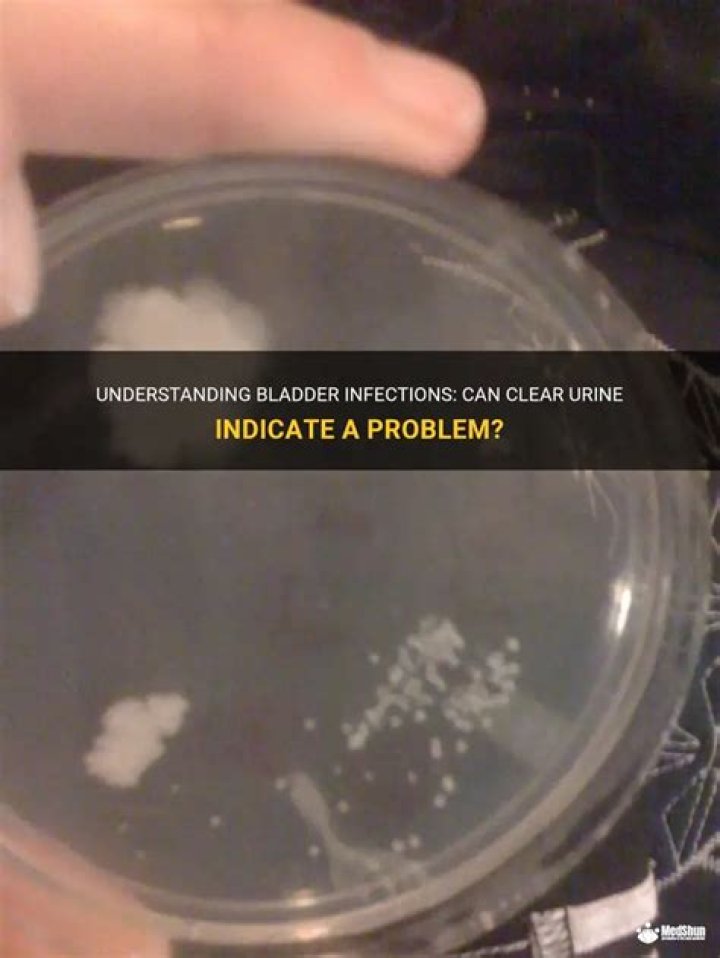

Can you have a bladder infection with clear urine?

Sarah Smith
Published Jan 15, 2026
Common UTI Symptoms and Signs
Can you have a UTI with clear urine?
If you've experienced a recent urinary tract infection, kidney stones, or other types of kidney injury, you should also contact a doctor if your urine appears very clear.
What can mimic a urinary tract infection?
There are several conditions whose symptoms mimic UTIs. Sexually transmitted infections (gonorrhea, chlamydia, and mycoplasma) cause symptoms also common in UTIs, such as painful urination and discharge.
What feels like a bladder infection but isn t?
Interstitial cystitis, or IC, is a mysterious, painful bladder condition with no known cause or cure. Patients typically experience symptoms resembling those of a urinary tract infection, minus the actual infection: the burning, the urgency, the constant need to pee, the overall pelvic pain and discomfort.
How can you tell the difference between a UTI and a bladder infection?
A UTI is defined as an infection in one or more places in the urinary tract—the ureters, kidneys, urethra, and/or bladder. A bladder infection is a UTI that's only located in the bladder.
30 related questions foundHow does a bladder infection feel?
Urinary tract infections don't always cause signs and symptoms, but when they do they may include: A strong, persistent urge to urinate. A burning sensation when urinating. Passing frequent, small amounts of urine.
What are the signs of a bladder infection in a woman?
Symptoms
- A strong, persistent urge to urinate.
- A burning sensation when urinating.
- Passing frequent, small amounts of urine.
- Blood in the urine (hematuria)
- Passing cloudy or strong-smelling urine.
- Pelvic discomfort.
- A feeling of pressure in the lower abdomen.
- Low-grade fever.
Can you have a bladder infection without burning?
If you're like most people, you probably think of burning or pain with urination being an unavoidable consequence of a UTI. In reality, many urinary tract infections do not cause painful urination, and some patients with UTIs are completely asymptomatic.
How do you know if something is wrong with your bladder?
Changes in bladder habits or symptoms of irritation
Having to urinate more often than usual. Pain or burning during urination. Feeling as if you need to go right away, even when your bladder isn't full. Having trouble urinating or having a weak urine stream.
Can the bowel press on the bladder?
If you're severely constipated, your bowel may become overfull and press on your bladder, reducing the amount it can hold or creating a need to pee. Surgery to part of your bowel or an injury to your spine may have damaged nerves to your bladder.
What is a silent UTI?
A silent UTI is just like a regular UTI, only without the typical symptoms that prove our immune system is fighting off the infection. That's why those with weaker immune systems, especially the elderly, are more prone to silent UTIs. Urinary tract infections are risky to begin with.
Why does my bladder hurt but no infection?
Interstitial cystitis (IC)/bladder pain syndrome (BPS) is a chronic bladder health issue. It is a feeling of pain and pressure in the bladder area. Along with this pain are lower urinary tract symptoms which have lasted for more than 6 weeks, without having an infection or other clear causes.
Where do you feel bladder pain?
Since the bladder sits in the middle of the body, bladder pain is usually felt in the center of the pelvis or lower abdomen as opposed to one side.
What does clear pee indicate?
Clear urine indicates that you're drinking more than the daily recommended amount of water. While being hydrated is a good thing, drinking too much water can rob your body of electrolytes.
Is slightly hazy urine normal?
In most cases, cloudy urine is harmless due to natural changes that your body goes through. Normally, it goes away quickly when you stay hydrated and incorporate a healthy diet into your daily routine. Reach out to your healthcare provider if you notice the cloudiness of your urine is not clearing up after a few days.
Why is my urine Colourless?
Colorless urine may indicate over-hydration. While not as dangerous as dehydration, over-hydration can dilute essential salts, such as electrolytes, creating a problematic chemical imbalance in the blood.
How do you check your bladder?
Cystoscopy (sis-TOS-kuh-pee) is a procedure that allows your doctor to examine the lining of your bladder and the tube that carries urine out of your body (urethra). A hollow tube (cystoscope) equipped with a lens is inserted into your urethra and slowly advanced into your bladder.
What is the fastest way to get rid of a bladder infection?
Most bladder infections are treated with antibiotics. This is the fastest way to get rid of a bladder infection.
...
Medications to treat bladder infections include:
- Nitrofurantoin (Macrobid)
- Trimethoprim-sulfamethoxazole (Bactrim)
- Fosfomycin (Monurol)
What is cystitis of urinary bladder?
Cystitis is inflammation of the bladder, usually caused by a bladder infection. It's a common type of urinary tract infection (UTI), particularly in women, and is usually more of a nuisance than a cause for serious concern. Mild cases will often get better by themselves within a few days.
What are the four possible causes of bladder infection?
Other risk factors include:
- sexual intercourse.
- age.
- using a spermicide for birth control.
- not urinating immediately after sexual intercourse.
- changes in the bacteria in the vagina.
- having a bladder or kidney infection within the past 12 months.
- changes in the urinary system.
- menopause.
What happens if a bladder infection is left untreated?
The main danger associated with untreated UTIs is that the infection may spread from the bladder to one or both kidneys. When bacteria attack the kidneys, they can cause damage that will permanently reduce kidney function. In people who already have kidney problems, this can raise the risk of kidney failure.
Which side is the bladder on?
The bladder sits in the center of the pelvis. If a person feels pain in the lower right or left abdomen, it is less likely to relate to the bladder and may signal kidney stones instead.
Can you have abdominal pain with a bladder infection?
Abdominal Pain
Pain from a bladder infection presents itself as a sharp or stabbing pain in the lower abdomen. If however, you begin to feel pain in the middle of your back, it could indicate that your infection has spread to your kidneys.
How do you soothe an irritated bladder?
Treatment
- Nonsteroidal anti-inflammatory drugs, such as ibuprofen (Advil, Motrin IB, others) or naproxen sodium (Aleve), to relieve pain.
- Tricyclic antidepressants, such as amitriptyline or imipramine (Tofranil), to help relax your bladder and block pain.
Do you get a bloated stomach with a UTI?
Urinary tract infection
UTIs typically cause bladder-specific symptoms like cloudy urine or pain when you urinate. However, the bacteria causing the infection can also affect your abdomen, specifically your lower abdomen. You may experience a lot of pressure and pain, and bloating can occur.



